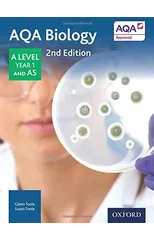
AQA Biology

Biology
Filtro

Pearson REVISE Edexcel GCSE Biology (Foundation) Revision Guide incl. online revision and quizzes - for 2026, 2027 exams
Pauline Lowrie
Multiple-com
Publicada:
2017